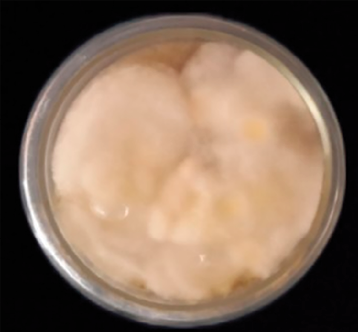

Введение
В последние годы перед человечеством особенно остро встают глобальные проблемы: нехватка продовольствия, загрязнение окружающей среды и ухудшение здоровья населения. Одним из эффективных путей их комплексного решения является развитие грибоводства. Промышленное культивирование съедобных и лекарственных грибов стремительно набирает обороты, что обусловлено рядом весомых факторов. Прежде всего, грибы обладают высокой биологической продуктивностью и считаются одной из самых урожайных культур. Они являются ценным источником полноценного белка, витаминов, микро- и макроэлементов, а также биологически активных веществ, обладающих лечебными свойствами. Кроме того, в процессе их выращивания используются отходы сельского и лесного хозяйства, а также перерабатывающей промышленности, что позволяет не только производить пищевые и лекарственные продукты, но и эффективно утилизировать органические отходы, снижая нагрузку на окружающую среду. Технология культивирования грибов отличается экологической чистотой, а само производство является практически безотходным. После сбора урожая использованный субстрат можно применять в качестве белково-витаминной добавки в корм для сельскохозяйственных животных или как органическое удобрение [1].
Грибы обладают высокой питательной ценностью, главным образом благодаря своему уникальному химическому составу. Они содержат большое количество пищевых волокон, имеют низкое содержание жиров, а также являются источником белков, витаминов и минеральных веществ, необходимых для сбалансированного рациона питания [2, 3]. Помимо этого, многочисленные исследования показали, что грибы богаты фитохимическими соединениями с выраженными антиоксидантными свойствами. Особенно ценными считаются фенольные соединения, обнаруженные в различных видах грибов, которые играют важную роль в защите организма от окислительного стресса [4]. Также были определены химические свойства н-гексановых, хлороформных и этилацетатных экстрактов плодовых тел T. versicolor [5, 6].
Грибы рода Trametes являются богатым источником биоактивных соединений с фармакологической активностью, включая антиоксидантные, противовоспалительные и противоопухолевые свойства. Исследования, проведенные на северо-западе Румынии, подтвердили, что два вида этого рода – T. versicolor (TV) и T. gibbosa (TG) – обладают значительной антиоксидантной активностью, высоким содержанием фенольных соединений и флавоноидов [7].
Для разработки процесса биоконверсии с использованием изолята T. versicolor в качестве ферментационного агента был применен экстракт виноградного сока, а для обогащения биомассы использовались глюкоза, фруктоза и их смесь [8]. Многие съедобные и несъедобные виды грибов с древности применяются в народной медицине, особенно в странах Восточной Азии. К числу грибов, из которых получены фармацевтические препараты с доказанным лечебным эффектом, относятся Ganoderma lucidum, Hericium erinaceus, Lentinus edodes, Schizophyllum commune, Tremella fusiformis, Trametes versicolor и Grifola frondosa [9–11]. Из T. versicolor были выделены полисахарид К (PSK) и полисахаридный пептид (PSP), которые в настоящее время изучаются как потенциальные средства дополнительной терапии при онкологических заболеваниях [12]. Кроме того, была исследована активность лакказы, выделенной из T. versicolor, в отношении различных синтетических красителей и промышленных отходов, что открывает перспективы применения гриба в биотехнологии и экологии [13]. Траметес разноцветный – лекарственный гриб, известный во всем мире своими полисахаридами PSP (полисахарид-пептид) и PSK (кресцин). Эти полисахариды в основном используются в Китае и Японии в качестве адъювантной терапии онкологических больных [14]. Исследование было проведено на Trametes sp. в Гималайском регионе. Изучены фитохимические соединения, полисахариды (в частности, β-глюкан) и антиоксидантная активность мицелиальной биомассы и плодового гриба-проволочника. Результаты показывают, что экстракт биомассы содержит значительное количество сапонинов, антрахинонов, фенолов, флавоноидов и β-глюканов. Также отмечена высокая антиоксидантная активность и эффективная нейтрализация радикалов DPPH [15].
Высшие базидиомицеты являются не только пищей, но и источником онкостатических, противовирусных и иммуномодулирующих полисахаридов. В исследованиях было изучено 20 штаммов 17 видов, при этом наибольшее количество эндополисахаридов было обнаружено у Ganoderma lucidum 1900 (4,4–8 %), а экзополисахаридов – у Trametes versicolor 353 (2,2 г/л). Оба вида отмечены как перспективные продуценты [16]. Неочищенный экстракт лакказы T. versicolor использовался при очистке сточных вод, удалении лигнина из лигноцеллюлозы и различных биотрансформациях [17]. Виды Trametes в целом обладают значительным лечебным потенциалом, который может быть связан с антиоксидантной и цитотоксической активностью. Кроме того, базидиокарпий и экстракты мицелия могут мощно ингибировать активность ацетилхолинэстеразы и тирозиназы [18].
На территории Узбекистана произрастает около 400 видов макромицетов, среди которых встречаются съедобные, лекарственные, ядовитые, а также дереворазрушающие виды. Первые научные исследования макромицетов в республике были проведены Т.С. Панфиловой и соавт. (1963) [19], а в дальнейшем продолжены (З.Р. Ахмедова и др. (2022) [20], I.M. Mustafaev и др. (2025) [21]. Указанные работы в основном сосредоточены на изучении флористического разнообразия и экологических особенностей грибов. Однако практическому значению лекарственных макромицетов, в том числе их фармакологическим свойствам и возможностям применения в медицине и пищевой промышленности, до настоящего времени уделялось недостаточное внимание, что подчеркивает актуальность дальнейших исследований в этом направлении.
Цель исследования – изучение распространения гриба Trametes versicolor на территории Узбекистана, а также выделение и получение чистой культуры данного вида в лабораторных условиях.
Материалы и методы исследования
В период с 2020 по 2024 г. были организованы сезонные научные поездки по Кашкадарьинской, Джиззакской и Наманганской областям Республики Узбекистан с целью сбора образцов макромицетов. Идентификация собранных макромицетов проводилась в лабораторных условиях с использованием цифрового микроскопа B-382PHiALC DC6V1000 mA для приготовления временных препаратов.
Для выделения чистой культуры гриба Trametes versicolor использовались методы экспериментальной микологии и микробиологии [22, 23]. В качестве питательной среды для выделения чистых культур использовали агар с солодовым экстрактом (МЭА), состав: 20 г солодового экстракта, 20 г агара, дистиллированная вода до 1000 мл. Для этого отбирался неповрежденный участок плодового тела гриба, который затем промывался в проточной воде для удаления посторонних частиц. Из внутренней ткани плодового тела с использованием стерилизованного скальпеля отрезался небольшой кусочек размером 0,5–1,5 см, который предварительно обрабатывался 3 % раствором перекиси водорода в течение нескольких секунд. После этого фрагмент гриба высаживался на питательную среду в чашки Петри, которые затем инкубировались в термостате при температуре 25 °C.
Результаты исследования и их обсуждение
Сбор и анализ материала проводился маршрутным методом, при котором по заранее определенным маршрутам фиксировались местообитания и экологические условия произрастания макромицетов. Для описания морфологических особенностей макромицетов в естественных условиях использовались фотографии, полученные с помощью цифровой камеры SD № 50. Гербарные образцы были сохранены в микологическом гербарии лаборатории микологии и альгологии Института ботаники (ТАСМ), а также в гербарии лаборатории микробиологии и биотехнологии Каршинского государственного университета.
Trametes versicolor был обнаружен на стволах тополей и других лиственных пород в Китабском и Яккабагском районах Кашкадарьинской области, а также в Ташкентской, Наманганской, Диззакской областях.
Плодовое тело гриба имеет пеструю верхнюю поверхность с открытым краем. Шляпка грибов обладает толщиной 1–3 мм и кожистой текстурой. Гриб растет группами или рядами на стволах и ветвях деревьев, образуя ярусные структуры. Размеры шляпки составляют 8×5×0,5–1 см (рис. 1).

Рис. 1. Trametes versicolor: А – на сломанных стволах ореха, Б – на пеньке тополя Источник: составлено авторами по результатам данного исследования
Trametes versicolor (трутовик разноцветный) – широко распространенный ксилотрофный гриб, который чаще всего растет на разлагающихся древесных остатках, таких как упавшие деревья и заброшенные пни лиственных пород. Иногда его можно обнаружить на стволах и ветвях ослабленных живых деревьев. Плодовое тело этого гриба сросшееся, образующее замкнутые слои, переплетенные между собой. Размеры плодового тела могут достигать 4–6 см в длину и 6–9 см в ширину. Цветовая гамма плодового тела весьма разнообразна и включает сочетания черного, коричневого, темно-желтого, белого и голубоватого оттенков. Форма плодового тела варьирует, однако чаще всего оно имеет веерообразную или круглую форму. На ощупь гриб нежный и шелковистый. Поверхность плодового тела извилистая, с различными оттенками. Цвета варьируются от серого, желтоватого, голубоватого до коричневого, причем край шляпки обычно светлее центра. Основание плодового тела часто имеет зеленоватый оттенок. Рост гриба T. versicolor на питательной среде начался через 2–3 дня после высаживания на питательную среду МЭА (агар с солодовым экстрактом). Характер роста мицелия был интенсивным, и через 15 дней инкубации было установлено, что оптимальной температурой для его роста является 25 °C (рис. 2).
Рис. 2. Trametes versicolor, чистая культура Источник: составлено авторами по результатам данного исследования
Мицелий в чашках Петри был белого цвета и демонстрировал радиальный рост, то есть он рос почти равномерно во всех направлениях. Суточный прирост мицелия составил 0,6–0,8 см. Было отмечено, что мицелий прикрепился к субстрату и разросся густо. Выращивание плодовых тел проводилось на двух различных питательных средах.
Trametes versicolor является одним из важнейших макромицетов с медицинской точки зрения. Лечебные свойства этого гриба включают расширение кровеносных сосудов, снижение артериального давления, повышение иммунного ответа и восстановление функции печени. Антиоксиданты и биоактивные соединения, содержащиеся в T. versicolor, способствуют регенерации клеток печени, нейтрализуют токсины и предотвращают накопление желчи. Спиртовые экстракты гриба замедляют рост клеток рака предстательной железы, чувствительных к андрогенам, и снижают уровень простат-специфического антигена (ПСА). Эти свойства делают T. versicolor перспективным в лечении заболеваний, связанных с гормональным дисбалансом. Кроме того, гриб может усиливать действие химиотерапевтических препаратов и уменьшать их побочные эффекты [24].
На территории Узбекистана T. versicolor был зафиксирован в следующих локациях: Ташкентская область, Юго-Западный Тянь-Шань, село Хумсан (координаты: N41.69404, E69.93829); Наманганская область, бассейн реки Чадаксай (N40.973942, E70.753598); Джизакская область, хребет Нуратау, Нуратинский заповедник (N40.51787, E66.75070); Зааминский национальный природный парк (N39.738386, E68.434676); Кашкадарьинская область, Яккабагский район (N38.887642, E66.784704) (рис. 3).
Trametes versicolor содержит β-глюканы, обладающие выраженными иммуномодулирующими свойствами. В Японии полисахаридный комплекс крестин (PSK), а также его аналоги, например Copolang в Южной Корее, широко применяются в клинической онкологии в качестве вспомогательных препаратов. Эти соединения активируют Т-лимфоциты, естественные киллеры (NK-клетки) и макрофаги, тем самым повышая общий иммунный статус организма и снижая токсические эффекты химиотерапии и радиотерапии. В Китае аналогичный препарат (IPPV) показал высокую эффективность при лечении заболеваний печени, особенно цирроза и вирусного гепатита. Благодаря способности усиливать иммунный ответ и подавлять воспалительные процессы, T. versicolor рассматривается как перспективный объект не только для онкологии, но и для гепатологии [25]. В целом оптимальные условия культивирования для роста мицелия и образования плодовых тел, микохимические соединения и цитотоксическое действие T. versicolor, представленные в таблице в данном исследовании, предоставляют важные данные, проливающие свет на ценность этого гриба для фармацевтической промышленности [26].

Рис. 3. Карта распространения Trametes versicolor в Узбекистане Источник: составлено авторами по результатам данного исследования
Таким образом, можно отметить, что T. versicolor является одним из наиболее часто встречающихся макромицетов на территории Узбекистана. Данный вид обладает высоким инновационным потенциалом и может быть использован в качестве продуцента биологически активных веществ, в том числе для разработки функциональных пищевых добавок и создания технологических решений для их производства в условиях республики.
Заключение
В последние годы наблюдается значительное увеличение научного и прикладного интереса к базидиомицетам, в частности к T. versicolor. Биологически активные соединения, содержащиеся в этом макромицете, обладают выраженными фармакологическими свойствами, что делает его перспективным источником для разработки новых лекарственных препаратов и функциональных биологически активных добавок.
Научные исследования, направленные на изучение распространения, морфологических и других характеристик T. versicolor, были проведены в сотрудничестве с лабораторией микологии и альгологии Института ботаники Академии наук Республики Узбекистан и Каршинским государственным университетом. Полученные результаты подтверждают широкое распространение этого вида на территории Узбекистана, а также его высокую биологическую ценность.
Trametes versicolor представляет значительный инновационный интерес для фармацевтической и биотехнологической отраслей Узбекистана. Расширение исследований в данной области открывает возможности для создания новых отечественных лекарственных средств и биологически активных добавок на основе местного сырья. Это не только усилит потенциал национальной фармацевтической промышленности, но и будет способствовать улучшению качества жизни населения, профилактике и лечению различных заболеваний.
Кроме того, использование T. versicolor как сырьевой базы для разработки импортозамещающей продукции позволит снизить зависимость от внешних поставок и обеспечить устойчивое развитие отечественного производства на базе природных ресурсов республики.


science-review.ru